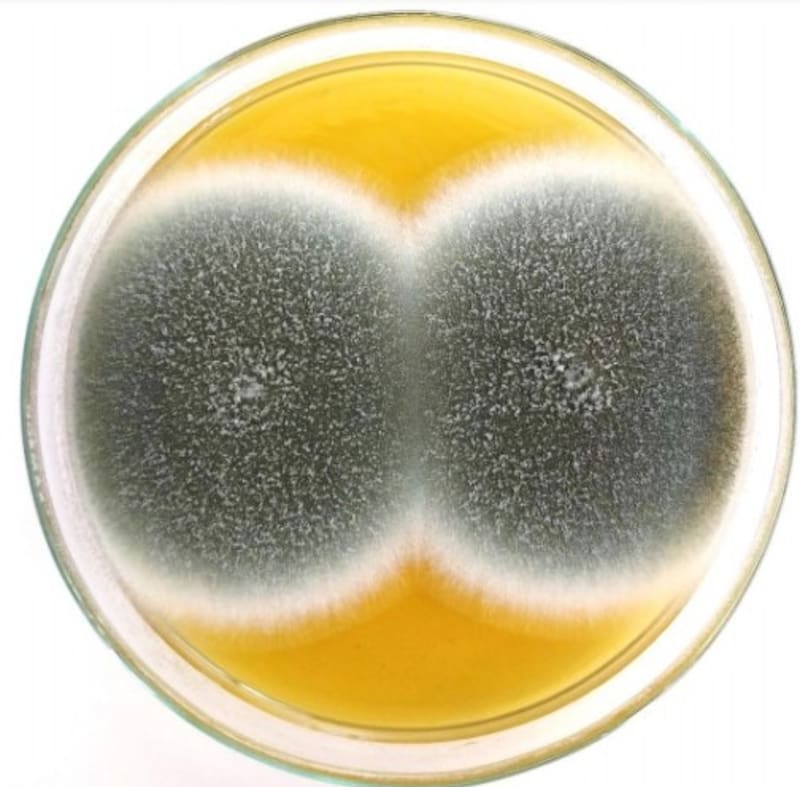

Siguen apareciendo casos de pacientes con hongo negro en Chile: ¿deberíamos preocuparnos?
La coinfección de estos patógenos oportunistas en personas que están con ventilación mecánica está aumentando en todo el mundo, incluido Chile, que pueden aumentar el riesgo de muerte.

Negros o verdes. Son de diferente origen y al microscopio también poseen distinto aspecto, forma y color. También tienen en común que están presentes siempre en el medioambiente, pero la presencia de cualquiera de ellos en un paciente que está con ventilación mecánica representa mayor riesgo de mortalidad.
Hoy debido a la pandemia de Covid-19, se están viendo más casos asociados a esta enfermedad pero no producidos directamente por ella, sino por los corticoides que en algunos casos se utilizan como parte del tratamiento.
La alerta masiva la dio India hace algunas semanas cuando en los medios de comunicación comenzaron a publicar notas acerca de un temido “hongo negro” que produce mucormicosis. Los casos se dispararon, tanto así, que ese país se habla de una “epidemia de hongo negro” y los medicamentos (antifúngicos), escasean.
Pero este tipo de hongos es fácil verlos en su cocina. Sobre todo en los alimentos descompuestos, cuando un limón o un tomate se pasan de maduros o comienzan a pudrirse, esa mancha negra o verde metálica es similar a los hongos que están produciendo las micosis en los pacientes con Covid-19 y se parecen mucho a lo que ven los médicos en los pulmones de los pacientes afectados.

Oportunistas
El jefe de Infectología de Clínica Alemana y micólogo (infectólogo especialista en Micología), Luis Thompson, explica que se trata de hongos oportunistas que se presentan como infección hace muchos años en el mundo, que han aumentado en los últimos 20 años porque la tecnología permite la ventilación mecánica de más personas y que ahora, producto de la pandemia se ven más casos.
No son frecuentes, pero pueden afectar a personas inmunodeprimidas, pacientes con leucemia mieloide aguda, trasplantados de órganos, con EPOC o cualquier otra alteración del sistema inmune, explica Thompson. En ningún caso, advierte, es nuevo lo que se está viendo en pacientes ventilados con Covid-19.
El infectólogo Rodrigo Cruz, director del Centro de Diagnóstico e Investigación de Enfermedades Infecciosas de la Universidad de Valparaíso, señala que estos hongos oportunistas se pueden dividir en dos grupos.
“Los hongos del orden Mucorales, son hongos basales o inferiores, ya que en sus hifas ( células fungícas) no tienen septos o separaciones. Son de rápido crecimiento por lo que su diagnóstico y tratamiento debe ser rápido. Entre ellos, el género Rhizopus es el más frecuente. Se conocen como hongo negro y son causantes de mucormicosis”, indica.
El otro grupo, es el del hongo verde. “Son los hongos más frecuentes entre los pacientes inmunodeprimidos y se conocen como superiores. Los más comunes son los aspergillus y producen aspergilosis”, dice Cruz.
Los conocidos como hongo verde están siempre en el medioambiente, “los estamos respirando, pero si hay una buena inmunidad, no pasa nada”, insiste Thompson. Respecto de los hongos mucorales o negro, explica que son infecciones que se conocen hace tiempo en Chile, sobre todo en pacientes con diabetes mal controlada en los que puede provocar ocasionalmente infección rinoorocerebral (nariz, ojo, cerebro)”.
Casos de pacientes Covid afectados con hongo verde, solo en la Región de Valparaíso, se han detectado al menos 12 durante toda la pandemia. Hongo negro, ya se conocen algunos, uno de ellos en un paciente hospitalizado en el Hospital del Tórax, en Santiago.
“Las sobreinfecciones por hongos se encuentran dentro de las complicaciones que pueden afectar a pacientes con cuadros graves. Las más frecuentes son las infecciones por levaduras como Candida spp. y por hongos filamentosos como Aspergillus spp. y agentes de mucormicosis, entre otros”, declaró la Sociedad Chilena de Infectología. También reconocieron que en el país “se han detectado casos de infección por hongos desde inicios de la pandemia” y como los casos han ido en aumento, suben también los pacientes graves en UCI y con ello las infecciones por hongo.
“Su diagnóstico requiere alto grado de sospecha clínica, estudio microbiológico dirigido con cultivos y marcadores de infección fúngica, y su tratamiento se basa en fármacos antifúngicos por períodos de varias semanas”, explicaron.
¿El problema?: los corticoides
“El principal problema es que son infecciones muy destructivas, avanzan rápidamente y se asocian a mucha mortalidad. En los pacientes que están graves, con Covid-19, en ventilación mecánica o conectados a ECMO, reciben grandes dosis de corticoides”, dice Thompson
La razón de estos corticoides es disminuir la inflamación que genera el sistema inmune como respuesta al virus Sars-CoV-2, pero junto con reducirla, también deja expuesto al paciente a bacterias y hongos oportunistas.
Lo nuevo, insiste Thompson, es que ahora los casos de aspergilosis y mucormicosis se están viendo en casos asociados a Covid-19.
A juicio de Cruz, hoy no existe una real magnitud del problema, nadie cuenta los casos pero todos saben que están aumentando. “Estos hongos los diagnosticábamos en inmunocomprometidos, pacientes graves por influenza, con cirrosis y ahora en pacientes ventilados con Covid”. Para él, es un motivo de preocupacion para los equipos médicos que deben estar muy atentos a su presencia porque suman mortalidad.
“Tener Covid-19 no es gratis. Podemos tener la forma leve, pero hay otras personas que pueden hacer una forma más grave, caer en ventilación mecánica y ellos están más expuestos a estas infecciones oportunistas y con más riesgo de morir”, indica Cruz.
No siempre se piensa en las infecciones fúngicas y esa es la preocupación del infectólogo de la U. de Valparaíso. “Hay que sospecharlo precozmente. Si un paciente ya lleva varios días ventilados, la neuomonía no mejora sino que aumenta se debe hacer una prueba para detectar y diagnosticar en forma precoz”.
Para detectar la presencia de estos hongos, se puede indicar un cultivo de aspirado traqueal o una prueba de galactomanano que es una proteína (antígeno) que está en la pared de los hongos y que se libera cuando hay infección. “Los hongos invaden las células de la parénquima pulmonar y además, invaden las arterias del pulmón. Finalmente, el pulmón termina con necrosis, se muere parte del tejido que se fibrosa y se pierde capacidad respiratorio”, dice Cruz.
COMENTARIOS
Para comentar este artículo debes ser suscriptor.
Lo Último
Lo más leído
1.
2.
3.
4.



















